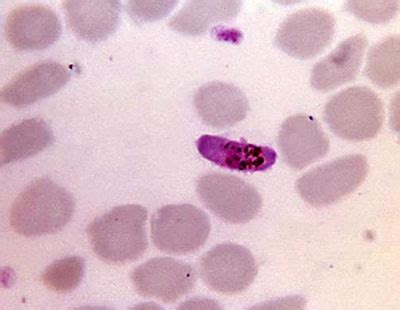
parasite science aaas

If you are looking for Parasite Bacteria you've come to the right place. We have 31 images about Parasite Bacteria including images, pictures, photos, wallpapers, and more. In these page, we also have variety of images available. Such as png, jpg, animated gifs, pic art, logo, black and white, transparent, etc.

Not only Parasite Bacteria, you could also find another pics such as
Commensalism,
Mutualism,
Symbiosis,
Virus,
Fungus,
Ecosystem,
Parasitoid,
Parasitic Plant,
Lichen,
Parasitology,
Vector,
Cleaner Fish,
Poster Design,
Red 40,
Movie Stills,
Movie Plot,
Black White,
Dong Ik,
Under Microscope,
Movie Cast,
Wallpaper 4K,
Living Room,
Basa Fish,
and Horsehair Worm.
 900×900 distinguish bacteria virus parasite sixmd from sixmd.com
900×900 distinguish bacteria virus parasite sixmd from sixmd.com
 800×800 parasite bacteria difference comparison from askanydifference.com
800×800 parasite bacteria difference comparison from askanydifference.com
 700×372 difference parasite bacteria biomadam from www.biomadam.com
700×372 difference parasite bacteria biomadam from www.biomadam.com
 768×512 parasite bacteria key differences explained from microbe-investigations.com
768×512 parasite bacteria key differences explained from microbe-investigations.com
 400×300 parasite prevention from clearviewanimal.com
400×300 parasite prevention from clearviewanimal.com
 553×311 parasite pictures images unsplash from unsplash.com
553×311 parasite pictures images unsplash from unsplash.com
 342×241 parasite summary main topic studied dr clark parasites info from parasite-zapper.net
342×241 parasite summary main topic studied dr clark parasites info from parasite-zapper.net
 992×661 prokaryotic microorganism parasite bacteria bacillus bacterium from www.dreamstime.com
992×661 prokaryotic microorganism parasite bacteria bacillus bacterium from www.dreamstime.com
 549×640 microbe parasite biology royalty stock illustration from pixabay.com
549×640 microbe parasite biology royalty stock illustration from pixabay.com
 600×405 parasite bfd resource centre from resources.beesfordevelopment.org
600×405 parasite bfd resource centre from resources.beesfordevelopment.org
 400×310 parasite science aaas from www.science.org
400×310 parasite science aaas from www.science.org
 1920×1080 obligate parasite definition examples biology dictionary from www.biologyonline.com
1920×1080 obligate parasite definition examples biology dictionary from www.biologyonline.com
 924×1232 parasite protocol symptoms treatment prevention understory healing from understoryhealing.com
924×1232 parasite protocol symptoms treatment prevention understory healing from understoryhealing.com
 707×333 parasite cleansing from immunoclean.com
707×333 parasite cleansing from immunoclean.com
 320×180 parasitepptx from www.slideshare.net
320×180 parasitepptx from www.slideshare.net
 850×479 tiny parasite solve wastewater problem from cosmosmagazine.com
850×479 tiny parasite solve wastewater problem from cosmosmagazine.com
 1200×800 horror woman shares symptoms discovered moms year from www.newsweek.com
1200×800 horror woman shares symptoms discovered moms year from www.newsweek.com
 850×638 parasite researchgate from www.researchgate.net
850×638 parasite researchgate from www.researchgate.net
 2048×2025 quarterly parasite cleanse black walnut klockwise creations from klockwisecreations.com
2048×2025 quarterly parasite cleanse black walnut klockwise creations from klockwisecreations.com
 1000×653 parasitic bacteria stock footage hd video clips alamy from www.alamy.com
1000×653 parasitic bacteria stock footage hd video clips alamy from www.alamy.com
 448×294 youths educate community parasite yourcommonwealth from yourcommonwealth.org
448×294 youths educate community parasite yourcommonwealth from yourcommonwealth.org
 1500×650 parasite faqs from www.faqs.com.pk
1500×650 parasite faqs from www.faqs.com.pk
 1920×1080 immunology microbiology parasite overview ditki medical from ditki.com
1920×1080 immunology microbiology parasite overview ditki medical from ditki.com
 800×420 medical laboratory biomedical science sunday parasite challenge from clinical-laboratory.blogspot.com
800×420 medical laboratory biomedical science sunday parasite challenge from clinical-laboratory.blogspot.com
553×400 difference parasites bacteria classification cellular from pediaa.com
553×400 difference parasites bacteria classification cellular from pediaa.com
 1540×800 parasite orders dinner researchers discover from www.infectioncontroltoday.com
1540×800 parasite orders dinner researchers discover from www.infectioncontroltoday.com
 1024×538 natural parasite solution listen gut from blog.listentoyourgut.com
1024×538 natural parasite solution listen gut from blog.listentoyourgut.com
 500×583 parasite tb infections worse science from www.science20.com
500×583 parasite tb infections worse science from www.science20.com
 768×512 parasite infection symptoms treatment prevention life love from lifebylove.nz
768×512 parasite infection symptoms treatment prevention life love from lifebylove.nz
 400×267 parasite test parasite alane wincek from medium.com
400×267 parasite test parasite alane wincek from medium.com
 1400×1104 parasite research papers encourage reproducibility scienc microbiology from www.labroots.com
1400×1104 parasite research papers encourage reproducibility scienc microbiology from www.labroots.com
Don't forget to bookmark Parasite Bacteria using Ctrl + D (PC) or Command + D (macos). If you are using mobile phone, you could also use menu drawer from browser. Whether it's Windows, Mac, iOs or Android, you will be able to download the images using download button.